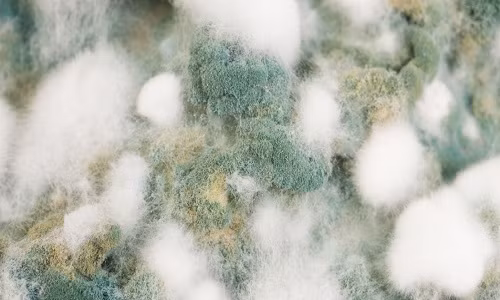

![]() |
| Ngày càng nhiều những con hươu ở Mỹ mắc bệnh dịch "xác sống". |
Theo RT, bệnh hươu zombie (CWD) khiến những con hươu mất kiểm soát, điên cuồng, sút cân và thậm chí tử vong.
Giống như bệnh bò điên, CWD tấn công não bộ và tủy sống của con vật, để lại những di chứng nặng nề. Những con hươu bị nhiễm bệnh trải qua những đau đớn khủng khiếp, nhưng quá trình ủ bệnh có khi diễn ra tới vài năm.
Một số nhà khoa học bày tỏ lo ngại về một ngày nào đó, CWD sẽ lây lan từ hươu sang người. Bệnh dịch này hiện đang lan tràn ở 24 bang Mỹ và Canada.
Minnesota hiện là bang bị bệnh dịch lây lan dữ dội nhất. Các thợ săn hầu như không thể biết được con hươu nào nhiễm bệnh, trong khi vẫn mang thịt về nhà nấu ăn như thường.
Chính quyền Canada đã phát cảnh báo, khuyến cáo người dân không nên ăn thịt hươu mắc bệnh.
“Điều này có thể sớm muộn cũng xảy ra, khi chúng đủ khả năng lây lan sang người”, Mark Zabel, giám đốc Viện Nghiên cứu Prion ở Đại học bang Colordo nhận định.
Trong quá khứ, các chuyên gia từng không tin bệnh bò điên có thể lây lan sang người, cho đến khi có người ăn thịt bò điên bị mắc bệnh vào năm 1996.
Tỷ lệ mắc CWD đặc biệt cao ở cộng đồng hươu nuôi nhốt, lên tới 79%. Trong tự nhiên, cứ một trong 4 con hươu có dấu hiệu mắc bệnh.
Tỷ lệ mắc bệnh tăng vọt ở bang Minnesota khiến các nhà khoa học lo ngại. Họ có kế hoạch phát triển thiết bị kiểm tra nhanh trên cả cá thể sống và đã chết.